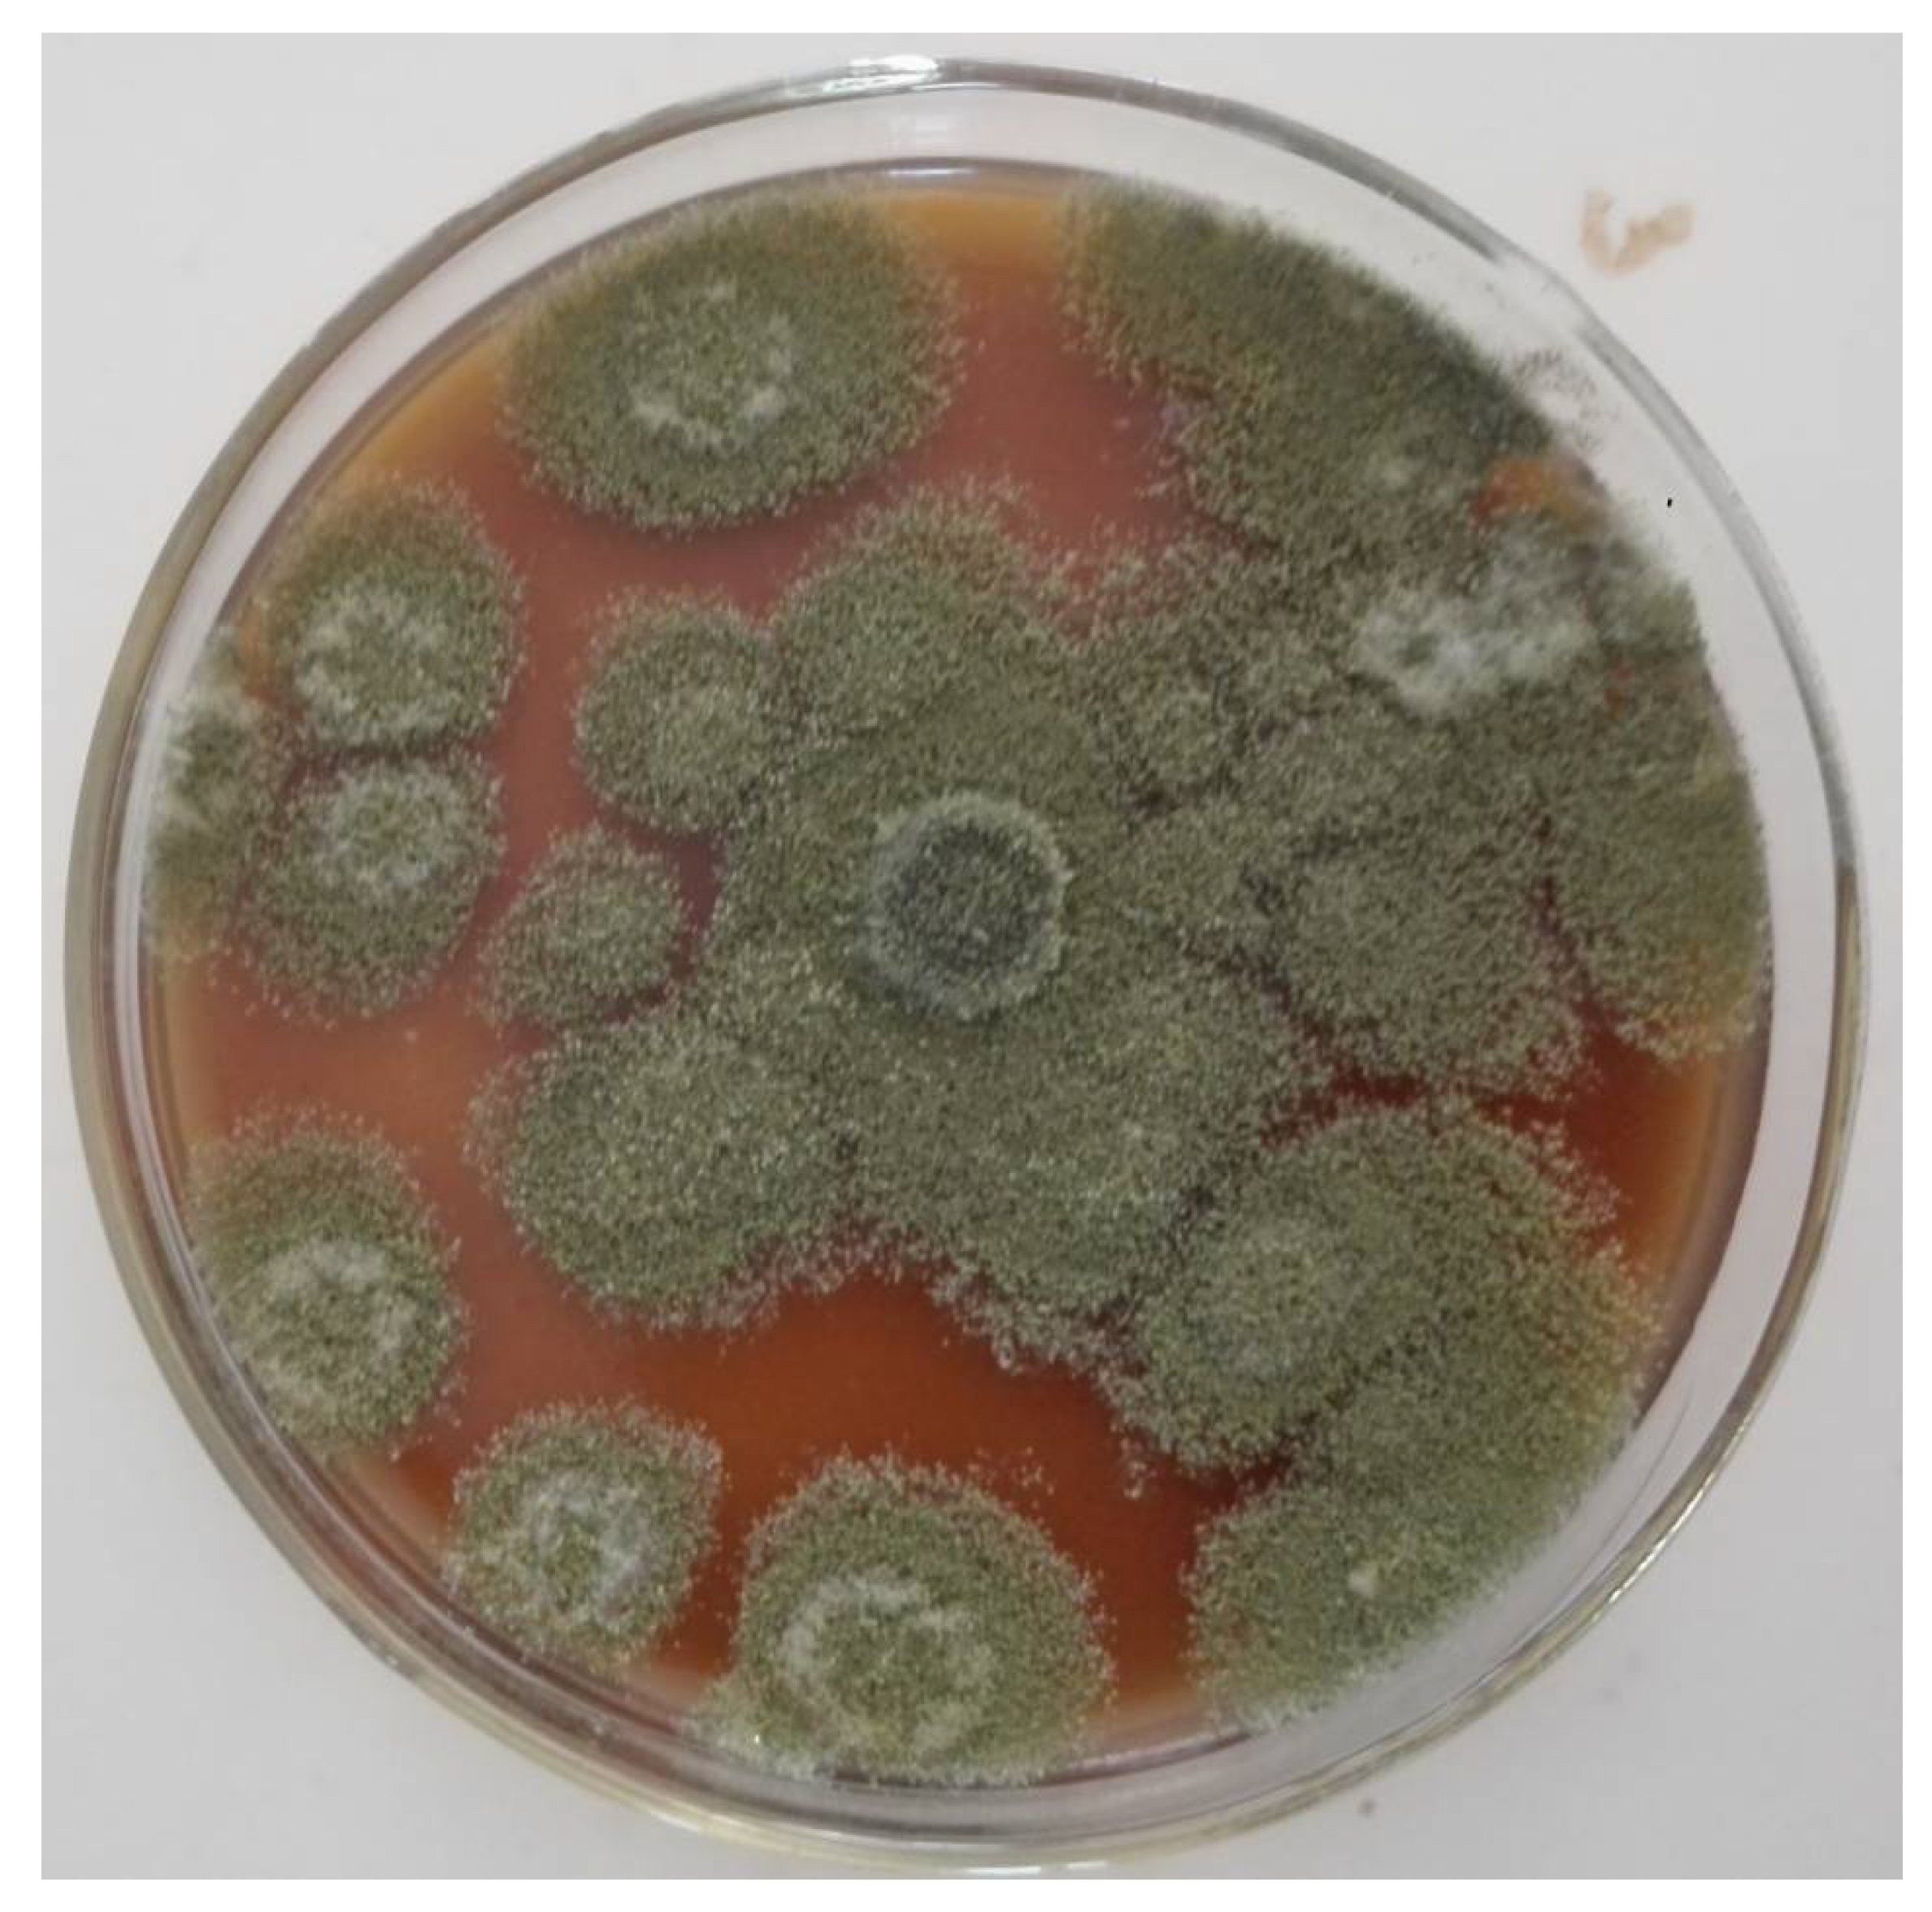

Immobilization of Fungal Peroxidase on Paramagnetic Nanoparticles for Synthetic Dye Decolorization †
Abstract
:1. Introduction
2. Materials and Methods
2.1. Materials
2.2. Methods
2.2.1. Peroxidase Production
2.2.2. Optimization of Fungal Medium for Peroxidase Production
2.2.3. Time Course Study for Peroxidase Production
2.2.4. Peroxidase Purification and Molecular Weight Determination
2.2.5. Enzyme Activity Assay
2.2.6. Phylogenetic Analysis of the Fungal Isolate Genome
2.2.7. Synthesis and Functionalization of Iron Oxide Magnetic Nanoparticles
2.2.8. Characterization of IOMNPs
2.2.9. Effect of Temperature and pH on Free and Immobilized Peroxidase’s Activities
2.2.10. Effect of Free and Immobilized Peroxidase on Substrate Concentration
2.2.11. Effect of Organic Solvents on Peroxidase Activity
2.2.12. Synthetic Dye Decolorization by Free and Immobilized Peroxidase
3. Results
Identity of the Potent Fungal Isolate
4. Discussion
5. Conclusions
Author Contributions
Funding
Institutional Review Board Statement
Informed Consent Statement
Data Availability Statement
Conflicts of Interest
References
- Pandey, V.P.; Rani, J.; Jaiswal, N.; Singh, S.; Awasthi, M.; Shasany, A.K.; Tiwari, S.; Dwivedi, U. Chitosan immobilized novel peroxidase from Azadirachta indica: Characterization and application. Int. J. Biol. Macromol. 2017, 104, 1713–1720. [Google Scholar] [CrossRef] [PubMed]
- Patel, S.K.S.; Choi, S.H.; Kang, Y.C.; Lee, J.K. Eco-friendly composite of Fe3O4-reduced graphene oxide particles for efficient enzyme immobilization. ACS Appl. Mater. Interfaces 2017, 9, 2213–2222. [Google Scholar] [CrossRef] [PubMed]
- Patel, S.K.S.; Otari, S.V.; Li, J.; Kim, D.R.; Kim, S.C.; Cho, B.K.; Kalia, V.C.; Kang, Y.C.; Lee, J.K. Synthesis of cross-linked protein-metal hybrid nanoflowers and its application in repeated batch decolorization of synthetic dyes. J. Hazard. Mater. 2020, 347, 442–450. [Google Scholar] [CrossRef] [PubMed]
- Cui, J.D.; Cui, L.L.; Zhang, S.P.; Zhang, Y.F.; Su, Z.G.; Ma, G.H. Hybrid magnetic cross-linked enzyme aggregates of phenylalanine ammonia lyase from rhodotorula glutinis. PLoS ONE 2014, 9, e97221. [Google Scholar] [CrossRef] [PubMed] [Green Version]
- de Sousa, M.; Silva, G.B.; Pessela, B.C.; Gonçalves, L.R.B. Preparation of CLEAs and magnetic CLEAs of a recombinant L-arabinose isomerase for D-tagatose synthesis. Enzyme Microb. Technol. 2020, 138, 109566. [Google Scholar] [CrossRef] [PubMed]
- Vaghari, H.; Jafarizadeh-Malmiri, H.; Mohammadlou, M.; Berenjian, A.; Anarjan, N.; Jafari, N.; Nasiri, S. Application of magnetic nanoparticles in smart enzyme immobilization. Biotechnol. Lett. 2016, 38, 223–233. [Google Scholar] [CrossRef] [PubMed]
- Otari, S.V.; Patel, S.K.S.; Kim, S.Y.; Haw, J.R.; Kalia, V.C.; Kim, I.W.; Lee, J.K. Copper Ferrite Magnetic Nanoparticles for the Immobilization of Enzyme. Indian J. Microbiol. 2019, 59, 105–108. [Google Scholar] [CrossRef] [PubMed]
- Singh, R.K.; Tiwari, M.K.; Singh, R.; Lee, J.K. From protein engineering to immobilization: Promising strategies for the upgrade of industrial enzymes. Int. J. Mol. Sci. 2013, 14, 1232–1277. [Google Scholar] [CrossRef]
- Omeje, K.O.; Eze, S.O.O. Properties of partially purified peroxidase extracted from the fruit of Solanum spp grown in Enugu north (Variety A) and Plateau central (variety B) zones of Nigeria. Biokemistri 2018, 30, 1–12. [Google Scholar]
- Victor, C.C.; Omeje, K.O.; Eze, S.O.O.; Ezugwu, A.L.; Chilaka, F.C.; Onwurah, I.N.E.; Ukoha, P.O. Decolorization of synthetic dyes using partially purified peroxidase from green cabbage (Brassica oleracea). Songklanakarin J. Sci. Technol. 2019, 41, 783–787. [Google Scholar]
- Chung, Y.; Tannia, D.C.; Kwon, Y. Glucose biofuel cells using bi-enzyme catalysts including glucose oxidase, horseradish peroxidase and terephthalaldehyde crosslinker. Chem. Eng. J. 2018, 334, 1085–1092. [Google Scholar] [CrossRef]
- Lopes, G.R.; Pinto, D.C.G.A.; Silva, A.M.S. Horseradish peroxidase (HRP) as a tool in green chemistry. RSC Adv. 2014, 4, 37244–37265. [Google Scholar] [CrossRef]
- Zhang, F.; Zhang, W.; Zhao, L.F.; Liu, H. Degradation of phenol with horseradish peroxidase immobilized on ZnO nanocrystals under combined irradiation of microwaves and ultrasound. Desalin. Water Treat. 2016, 57, 24406–24416. [Google Scholar] [CrossRef]
- Balaji, V.; Arulazhagan, P.; Ebenezer, P. Enzymatic bioremediation of polyaromatic hydrocarbons by fungal consortia enriched from petroleum contaminated soil and oil seeds. J. Environ. Biol. 2014, 35, 521–529. [Google Scholar]
- Omeje, K.O.; Nnolim, N.E.; Ezema, B.O.; Ozioko, J.N.; Eze, S.O.O. Synthetic dyes decolorization potential of agroindustrial waste-derived thermo-active laccase from Aspergillus species. Biocatal. Agric. Biotechnol. 2020, 29, 101800. [Google Scholar] [CrossRef]
- Gilman, J.C.A. Manual of Soil Fungi, 2nd ed.; Iowa State College Press: Ames, IA, USA, 1971; pp. 448–456. [Google Scholar]
- Laemmli, U.K. Cleavage of structural proteins during the assembly of the head of bacteriophage T4. Nature 1970, 227, 680–685. [Google Scholar] [CrossRef]
- Switzer, R.C.; Merril, C.R.; Shifrin, S. A highly sensitive silver stain for detecting proteins and peptides in polyacrylamide gels. Anal. Biochem. 1979, 98, 231–237. [Google Scholar] [CrossRef]
- Eze, S.O.O. Kinetic analysis of the thermostability of peroxidase from African oil bean (Pentaclethra macrophylla Benth) seeds. J. Biochem. Technol. 2012, 4, 459–463. [Google Scholar]
- Pryce, T.M.; Palladino, S.; Kay, I.D.; Coombs, G.W. Erratum: Rapid identification of fungi by sequencing the ITS1 and ITS2 regions using an automated capillary electrophoresis system (Medical Mycology (2003) 41 (369-381)). Med. Mycol. 2004, 42, 93. [Google Scholar]
- Ranjbakhsh, E.; Bordbar, A.K.; Abbasi, M.; Khosropour, A.R.; Shams, E. Enhancement of stability and catalytic activity of immobilized lipase on silica-coated modified magnetite nanoparticles. Chem. Eng. J. 2012, 179, 272–276. [Google Scholar] [CrossRef]
- Cruz-Izquierdo, Á.; Picó, E.A.; López, C.; Serra, J.L.; Llama, M.J. Magnetic Cross-Linked Enzyme Aggregates (mCLEAs) of Candida antarctica lipase: An efficient and stable biocatalyst for biodiesel synthesis. PLoS ONE 2014, 9, e115202. [Google Scholar] [CrossRef]
- Rehman, H.U.; Nawaz, M.A.; Aman, A.; Baloch, A.H.; Qader, S.A.U. Immobilization of pectinase from Bacillus licheniformis KIBGE-IB21 on chitosan beads for continuous degradation of pectin polymers. Biocatal. Agric. Biotechnol. 2014, 3, 282–287. [Google Scholar] [CrossRef]
- Prajapati, J.; Dudhagara, P.; Patel, K. Production of thermal and acid-stable pectinase from Bacillus subtilis strain BK-3: Optimization, characterization, and application for fruit juice clarification. Biocatal. Agric. Biotechnol. 2021, 35, 102063. [Google Scholar] [CrossRef]
- Ahmed, N.E.; El Shamy, A.R.; Awad, H.M. Optimization and immobilization of amylase producedby Aspergillus terreus using pomegranate peel waste. Bull. Natl. Res. Cent. 2020, 44, 109. [Google Scholar] [CrossRef]
- Wang, F.; Terry, N.; Xu, L.; Zhao, L.; Ding, Z.; Ma, H. Fungal laccase production from lignocellulosic agricultural wastes by solid-state fermentation: A review. Microorganisms 2019, 7, 665. [Google Scholar] [CrossRef] [Green Version]
- Maktouf, S.; Neifar, M.; Drira, S.J.; Baklouti, S.; Fendri, M.; Châabouni, S.E. Lemon juice clarification using fungal pectinolytic enzymes coupled to membrane ultrafiltration. Food Bioprod. Process. 2014, 92, 14–19. [Google Scholar] [CrossRef]
- da Câmara Rocha, J.; da Silva Araújo, J.; de Paiva, W.K.V.; Ribeiro, E.S.S.; de Araújo Padilha, C.E.; de Assis, C.F.; dos Santos, E.S.; de Macêdo, G.R.; de Sousa Junior, F.C. Yellow mombin pulp residue valorization for pectinases production by Aspergillus niger IOC 4003 and its application in juice clarification. Biocatal. Agric. Biotechnol. 2020, 30, 101876. [Google Scholar] [CrossRef]
- Asgher, M.; Iqbal, H.M.N.; Irshad, M. Characterization of purified and xerogel immobilized novel lignin peroxidase produced from Trametes versicolor IBL-04 using solid state medium of corncobs. BMC Biotechnol. 2012, 12, 1–8. [Google Scholar] [CrossRef] [Green Version]
- Kumar, P.; Kamle, M.; Singh, J. Biochemical characterization of Santalum album (Chandan) leaf peroxidase. Physiol. Mol. Biol. Plants 2011, 17, 153–159. [Google Scholar] [CrossRef] [Green Version]
- Andriani, A.; Sukorini, A.; Perwitasari, U.Y. Enhancement of laccase production in a new isolated Trametes hirsuta LBF-AA017 by lignocellulosic materials and its application for removal of chemical dyes. IOP Conf. Ser. Earth Environ. Sci. 2019, 308, 012015. [Google Scholar] [CrossRef]
- Khatri, B.P.; Bhattarai, T.; Shrestha, S.; Maharjan, J. Alkaline thermostable pectinase enzyme from Aspergillus niger strain MCAS2 isolated from Manaslu Conservation Area, Gorkha, Nepal. Springerplus 2015, 4, 488. [Google Scholar] [CrossRef] [PubMed] [Green Version]
- Dange, V.; Harke, S. Production and purification of Pectinase by fungal strain in solid-state fermentation using agro-industrial bioproduct. World J. Microbiol. Biotechnol. 2018, 16, 277–282. [Google Scholar]
- Cardinali, A.; Sergio, L.; Di Venere, D.; Linsalata, V.; Fortunato, D.; Conti, A.; Lattanzio, V. Purification and characterization of a cationic peroxidase from artichoke leaves. J. Sci. Food Agric. 2007, 87, 1417–1423. [Google Scholar] [CrossRef]
- Sandri, I.G.; Lorenzoni, C.M.T.; Fontana, R.C.; da Silveira, M.M. Use of pectinases produced by a new strain of Aspergillus niger for the enzymatic treatment of apple and blueberry juice. LWT Food Sci. Technol. 2013, 51, 469–475. [Google Scholar] [CrossRef]
- Osuji, A.C.; Eze, S.O.O.; Osayi, E.E.; Chilaka, F.C. Biobleaching of industrial important dyes with peroxidase partially purified from garlic. Sci. World J. 2014, 2014, 183163. [Google Scholar] [CrossRef] [Green Version]
- Mohamed, S.A.; Abdel-Aty, A.M.; Hamed, M.B.; El-Badry, M.O.; Fahmy, A.S. Ficus sycomorus latex: A thermostable peroxidase. African J. Biotechnol. 2011, 10, 17532–17545. [Google Scholar]
- Yihong, H. Purification and partial characterization of peroxidase from lettuce stems. African J. Biotechnol. 2012, 11, 2752–2756. [Google Scholar] [CrossRef]
- Mall, R.; Naik, G.; Mina, U.; Mishra, S.K. Purification and characterization of a thermostable soluble peroxidase from citrus medica leaf. Prep. Biochem. Biotechnol. 2013, 43, 137–151. [Google Scholar] [CrossRef]
- Geng, Z.; Rao, K.J.; Bassi, A.S.; Gijzen, M.; Krishnamoorthy, N. Investigation of biocatalytic properties of soybean seed hull peroxidase. Catal. Today 2001, 64, 233–238. [Google Scholar] [CrossRef]
- Singh, P.; Prakash, R.; Shah, K. Effect of organic solvents on peroxidases from rice and horseradish: Prospects for enzyme based applications. Talanta 2012, 97, 204–210. [Google Scholar] [CrossRef]
- Chanwun, T.; Muhamad, N.; Chirapongsatonkul, N.; Churngchow, N. Hevea brasiliensis cell suspension peroxidase: Purification, characterization and application for dye decolorization. AMB Express 2013, 3, 1–9. [Google Scholar] [CrossRef] [Green Version]
- Liu, J.Z.; Wang, T.L.; Ji, L.N. Enhanced dye decolorization efficiency by citraconic anhydride-modified horseradish peroxidase. J. Mol. Catal. B Enzym. 2006, 41, 81–86. [Google Scholar] [CrossRef]
- Sofia, P.; Asgher, M.; Shahid, M.; Randhawa, M.A. Chitosan beads immobilized Schizophyllum commune IBL-06 lignin peroxidase with novel thermo stability, catalytic and dye removal properties. J. Anim. Plant Sci. 2016, 26, 1451–1463. [Google Scholar]

| Total Protein (mg) | Total Activity (U/min) | Specific Activity (U/min) % | Yield | Purif. Fold | |
|---|---|---|---|---|---|
| Crude | 482.81 | 7643 | 57.25 | 100 | 1.00 |
| Ammonium sulphate | 173.94 | 20569 | 118.25 | 74.40 | 2.06 |
| Ion exchange | 97.13 | 16599 | 170.89 | 60.04 | 2.98 |
| Gel filtration | 27.08 | 13746 | 507.60 | 49.72 | 8.86 |
| Free Enzyme Immobilized Enzyme | Guaiacol | Pyrogallol | Guaiacol | Pyrogallol |
|---|---|---|---|---|
| Km (mM) | 0.135 | 0.243 | 0.075 | 1.886 |
| Vmax (μmol/min) | 357.14 | 333.33 | 238.09 | 1000 |
| 2645.25 | 1371.74 | 3174.53 | 530.22 | |
| Kcat (Min−1) | 10.204 | 9.52 | 6.80 | 28.57 |
| Catalytic Efficiency (Mol/S−1) | 75.55 | 39.17 | 90.66 | 15.19 |
Publisher’s Note: MDPI stays neutral with regard to jurisdictional claims in published maps and institutional affiliations. |
© 2022 by the authors. Licensee MDPI, Basel, Switzerland. This article is an open access article distributed under the terms and conditions of the Creative Commons Attribution (CC BY) license (https://creativecommons.org/licenses/by/4.0/).
Share and Cite
Omeje, K.O.; Magbo, C.; Ossai, E.C.; Ozioko, J.N.; Ezema, B.O.; Nnolim, N.E.; Eze, S.O.O. Immobilization of Fungal Peroxidase on Paramagnetic Nanoparticles for Synthetic Dye Decolorization. Mater. Proc. 2022, 9, 24. https://doi.org/10.3390/materproc2022009024
Omeje KO, Magbo C, Ossai EC, Ozioko JN, Ezema BO, Nnolim NE, Eze SOO. Immobilization of Fungal Peroxidase on Paramagnetic Nanoparticles for Synthetic Dye Decolorization. Materials Proceedings. 2022; 9(1):24. https://doi.org/10.3390/materproc2022009024
Chicago/Turabian StyleOmeje, Kingsley O., Chinonso Magbo, Emmanuel C. Ossai, Juliet N. Ozioko, Benjamin O. Ezema, Nonso E. Nnolim, and Sabinus O. O. Eze. 2022. "Immobilization of Fungal Peroxidase on Paramagnetic Nanoparticles for Synthetic Dye Decolorization" Materials Proceedings 9, no. 1: 24. https://doi.org/10.3390/materproc2022009024
APA StyleOmeje, K. O., Magbo, C., Ossai, E. C., Ozioko, J. N., Ezema, B. O., Nnolim, N. E., & Eze, S. O. O. (2022). Immobilization of Fungal Peroxidase on Paramagnetic Nanoparticles for Synthetic Dye Decolorization. Materials Proceedings, 9(1), 24. https://doi.org/10.3390/materproc2022009024

